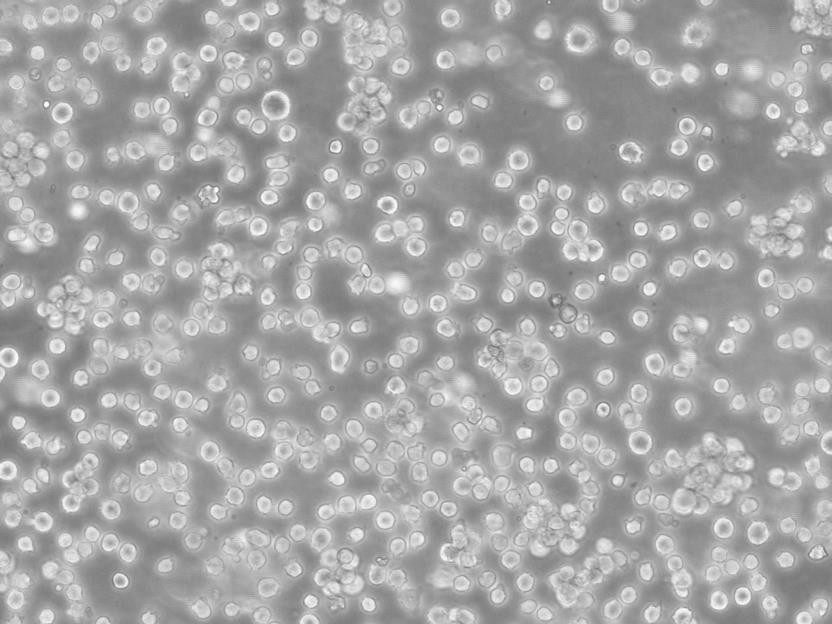
AC16人心肌复苏细胞|STR基因图谱

"AC16人心肌复苏细胞|STR基因图谱
传代比例:1:2-1:4(首次传代建议1:2)
生长特性:贴壁生长
换液周期:每周2-3次
DR2R1610 Cells;背景说明:详见相关文献介绍;传代方法:1:2-1:3传代;每周换液2-3次。;生长特性:贴壁或悬浮,详见产品说明书部分;形态特性:详见产品说明书;相关产品有:253J细胞、50.B1细胞、Tregs细胞
Colon38 Cells;背景说明:详见相关文献介绍;传代方法:1:2传代;生长特性:贴壁生长;形态特性:上皮细胞样;相关产品有:H125细胞、RC13细胞、JF305细胞
SVEC4-10 Cells;背景说明:详见相关文献介绍;传代方法:1:2-1:3传代;每周换液2-3次。;生长特性:贴壁或悬浮,详见产品说明书部分;形态特性:详见产品说明书;相关产品有:Hx147细胞、CORL88细胞、Hs 729.T细胞
【细胞培养经验分享】启蒙老师的重要性:一般进实验室都有师兄师姐带着做,他们就是你做细胞的启蒙老师。他们的操作手法、细节、理论讲解就成了你操作的准则,如营养液、细胞瓶的摆放位置、灭菌处理程序、开盖手法、细胞吹打手法等等。要学会他们的正确操作,在第一次的时候就要重视。像养孩子一样养细胞,细胞有时真的很脆弱,最好每天都去看看它,以防止出现培养箱缺水、缺二氧化碳、停电、温度不够等异常现象,也好及时解决这些意外,避免重复实验带来的更大痛苦。好细胞要及时保种:细胞要分批传代,这样即使有一批出了问题,还有一批备用的。像后者一般人可能不容易做到。但这是我血的教训,有一次细胞污染了,全军覆没。当时可后悔没有保种。细胞跟人一样,不同的细胞,培养特性是不一样的。培养过程中要细细体会,不同细胞系使用不同的培养基和血清。
AC16人心肌复苏细胞|STR基因图谱
背景信息:详见相关文献介绍
┈订┈购(技术服务)┈热┈线:1┈3┈6┈4┈1┈9┈3┈0┈7┈9┈1【微信同号】┈Q┈Q:3┈1┈8┈0┈8┈0┈7┈3┈2┈4;
贴壁细胞的传代培养,详细步骤如下:首先倒掉培养基,在这一步骤可以收集一些细胞上清做支原体检测;加入胰蛋白酶,一般T25是加2mL,盖好瓶盖,摇晃T25培养瓶,使胰蛋白酶均匀覆盖在细胞表面,放入培养箱2-3min,期间可在显微镜下观察,看到大部分细胞变圆,即可放入超净台,加入2倍的完全培养基,这里就是加4mL培养基,终止消化;将含有胰蛋白酶,细胞和培养基一起转移到离心管中,1000rpm/3min离心,去掉上清;新鲜的完全培养基重悬,根据细胞的生长特性和后续的实验需求进行传代,比如我养的Hepa1-6就长的比较快,不是着急用的话,我就会按1E6个细胞/T75培养瓶进行传代;但如果后两天要用,就会适当多传一点;还可通过显微镜计数后,直接用于细胞铺板,继续后续的实验。
产品包装:复苏发货:T25培养瓶(一瓶)或冻存发货:1ml冻存管(两支)
Ku812F Cells;背景说明:慢性粒细胞白血病;男性;传代方法:1:2-1:3传代;每周换液2-3次。;生长特性:悬浮;形态特性:详见产品说明书;相关产品有:159PT细胞、GC-2细胞、CD-18细胞
Caco 2 Cells;背景说明:细胞株分离自一个原发性结肠癌。当细胞长满时,表现出典型的肠细胞分化的特征。Caco-2细胞表达维生素A酸结合蛋白I和视黄醇结合蛋白II,角蛋白阳性。;传代方法:1:2-1:3传代;每周换液2-3次。;生长特性:贴壁;形态特性:上皮细胞样;相关产品有:HEM-L细胞、hSCC-25细胞、FRO细胞
BHP10-3 Cells;背景说明:甲状腺乳头状癌;女性;传代方法:1:2-1:3传代;每周换液2-3次。;生长特性:贴壁;形态特性:详见产品说明书;相关产品有:A375-SM细胞、MES23.5细胞、SKGT2细胞
T/GHA-VSMC Cells;背景说明:详见相关文献介绍;传代方法:1:2-1:3传代;每周换液2-3次。;生长特性:贴壁或悬浮,详见产品说明书部分;形态特性:详见产品说明书;相关产品有:SGC-7901细胞、NCIH441细胞、KOSC2细胞
AC16人心肌复苏细胞|STR基因图谱
来源说明:细胞主要来源ATCC、ECACC、DSMZ、RIKEN等细胞库
物种来源:人源、鼠源等其它物种来源
┈订┈购(技术服务)┈热┈线:1┈3┈6┈4┈1┈9┈3┈0┈7┈9┈1【微信同号】┈Q┈Q:3┈1┈8┈0┈8┈0┈7┈3┈2┈4;
形态特性:上皮细胞样
可以这样说,对于需要消化传代的细胞,每一次的消化都是对这个细胞存活与否,状态HAO与不HAO至关重要的考验。很多同学都遇到过这个问题,自己养的细胞开始的几代长的还挺HAO的,可是穿过几代之后就发现自己的细胞不行了,状态越来越差劲了。对于这个问题,可以非常肯定地说,你的消化环节出问题了。你每一次的消化都让细胞受到较大损伤了。所以,越长越差。在消化的过程中,你加入胰酶后,所有细胞都在被胰酶消化着,但是我们忽视了一个问题就是,细胞的生长状态是不一样的,每一个细胞的贴壁情况也是不一样的,有的贴壁牢固,有的贴壁没有那么牢固的,所以,让所有的细胞消化同样的时间对细胞是不公平的,他们受到了差别待遇当然会有脾气的,大家争取做到因材施教,比如试试下面的“四步消化法”。(以难消化细胞为例),具体操作:1)首先不加胰酶,倒掉旧培养基加入少量新培养基洗1-2遍(目的是将漂浮着的死细胞之类尽量洗掉)。2)然后再加入少量新培养基直接吹打一遍,这一遍是把贴壁不牢固的细胞吹打下来。再用培养基洗一遍,两次所得悬混合传入新瓶。(你可以将这些传入新瓶培养,以与后面胰酶消化过的细胞对比观察看谁长的更HAO一点就知道该细胞对胰酶的敏感度了)3)吸干净瓶内剩余体,加入0.3ml左右的胰酶润洗一遍,吸掉弃之,再加入1ml左右的胰酶消化。消化的同时置于显微镜下观察,待细胞与细胞之间间隙明显的时候立即吸掉胰酶,加入新培养基开始吹打,吹打2-3遍后吸取悬于试管或新瓶暂存。用2ml左右新培养基洗一遍与前面的混合。(也可以传入新瓶培养,以与后面及前面的做对比)4)然后把前面刚吸出来的胰酶重新加进去瓶里继续消化剩余的贴壁牢固的细胞。当然你也可以用新的胰酶,如果你们那比较富裕的话,继续镜下观察,待剩余细胞间隙明显,细胞独立开来的时候,吸掉胰酶,加入新培养基吹打。悬传入新瓶培养(根据实际情况把握)。
Hs 934.T Cells;背景说明:详见相关文献介绍;传代方法:1:2-1:3传代,;生长特性:贴壁或悬浮,详见产品说明书部分;形态特性:成纤维细胞;相关产品有:MV4-11细胞、NCIH2030细胞、G 401细胞
SW 1990 Cells;背景说明:胰腺癌;男性;传代方法:1:2-1:3传代;每周换液2-3次。;生长特性:贴壁;形态特性:详见产品说明书;相关产品有:MLE12细胞、NB19细胞、R2C细胞
Capan-2 Cells;背景说明:详见相关文献介绍;传代方法:1:2-1:4传代,2-3天换液1次。;生长特性:贴壁生长;形态特性:多边形;相关产品有:H-1341细胞、NOR 10细胞、NG10815细胞
NFHIOSE-80 Cells;背景说明:卵巢;上皮细胞;SV40转化;女性;传代方法:1:2-1:3传代;每周换液2-3次。;生长特性:贴壁;形态特性:详见产品说明书;相关产品有:Renal Proximal Tubule Epithelial Cells/TERT-immortalized 1细胞、RBL2H3细胞、COLO394细胞
HuTu-80 Cells;背景说明:详见相关文献介绍;传代方法:1:2—1:5传代,每周换液2-3次;生长特性:贴壁生长;形态特性:上皮细胞样;相关产品有:Alpha Mouse Liver 12细胞、3T3-L1 ad细胞、Vero from pool #76细胞
CCRF/CEM-C7 Cells;背景说明:急性T淋巴细胞白血病;女性;传代方法:1:2-1:3传代;每周换液2-3次。;生长特性:悬浮;形态特性:详见产品说明书;相关产品有:SLMT-1细胞、COLO206细胞、SCCVII/St细胞
SK-RC 52 Cells;背景说明:肾癌;纵隔膜转移;传代方法:1:2-1:3传代;每周换液2-3次。;生长特性:贴壁;形态特性:详见产品说明书;相关产品有:BLO11细胞、McCoy细胞、Vertebral Cancer of the Prostate细胞
Human fetal lung fibroblast 1 Cells;背景说明:详见相关文献介绍;传代方法:消化3-5分钟。1:2。3天内可长满。;生长特性:贴壁生长;形态特性:成纤维细胞样;相关产品有:OCI AML3细胞、LC-1 sq细胞、WM239细胞
T98 G Cells;背景说明:详见相关文献介绍;传代方法:按1:3传代;生长特性:贴壁生长;形态特性:详见产品说明书;相关产品有:Colon38细胞、MMQ细胞、32D.cl3细胞
MB231 Cells;背景说明:MDA-MB-231来自患有转移乳腺腺癌的51岁女病人的胸水。在裸鼠和ALS处理的BALB/c小鼠中,它能形成低分化腺癌(III级)。;传代方法:消化3-5分钟,1:2,3天内可长满;生长特性:贴壁生长;形态特性:上皮样;相关产品有:MKN 45细胞、KNS-81细胞、NRK 49F细胞
OCI-Ly 7 Cells;背景说明:弥漫大B淋巴瘤;男性;传代方法:1:2-1:3传代;每周换液2-3次。;生长特性:悬浮;形态特性:详见产品说明书;相关产品有:H220细胞、253J-BV细胞、Tsup-1细胞
NT2D1 Cells;背景说明:详见相关文献介绍;传代方法:1:2-1:3传代;每周换液2-3次。;生长特性:贴壁或悬浮,详见产品说明书部分;形态特性:详见产品说明书;相关产品有:GAK细胞、NL20SV细胞、D10细胞
MN-9D Cells;背景说明:多巴胺能神经元 Cells;传代方法:1:2-1:3传代;每周换液2-3次。;生长特性:贴壁;形态特性:详见产品说明书;相关产品有:Mono Mac6细胞、BT549细胞、H-2405细胞
GM17219 Cells;背景说明:B淋巴细胞;EBV转化;传代方法:1:2-1:3传代;每周换液2-3次。;生长特性:悬浮;形态特性:详见产品说明书;相关产品有:SUM159细胞、BT483细胞、Hs-852-T细胞
NCI-H2452 Cells;背景说明:详见相关文献介绍;传代方法:消化3-5分钟。1:2。3天内可长满。;生长特性:贴壁生长;形态特性:上皮样;相关产品有:SKMEL28细胞、L1210细胞、SCC-4细胞
Los Angeles Prostate Cancer-4 Cells;背景说明:前列腺癌;淋巴结转移;男性;传代方法:1:2-1:3传代;每周换液2-3次。;生长特性:贴壁;形态特性:详见产品说明书;相关产品有:SF295细胞、HKBML细胞、HRVEC细胞
HEC1-A Cells;背景说明:这株细胞及其亚株HEC-1-B是H.Kuramoto及其同事1968年从一位IA期子宫内膜癌患者身上分离得到的。PAF可以诱导其c-fos的表达。;传代方法:消化3-5分钟,1:2,3天内可长满;生长特性:贴壁生长;形态特性:上皮样;相关产品有:C33A细胞、hA549细胞、LAPC-4细胞
AC16人心肌复苏细胞|STR基因图谱
A-388 Cells(提供STR鉴定图谱)
Abcam MCF-7 PAX5 KO Cells(提供STR鉴定图谱)
B'SYS CHO Kir2.1 Cells(提供STR鉴定图谱)
BayGenomics ES cell line RRO411 Cells(提供STR鉴定图谱)
BayGenomics ES cell line YHC014 Cells(提供STR鉴定图谱)
CDIi010-A Cells(提供STR鉴定图谱)
DA01189 Cells(提供STR鉴定图谱)
FES 30 Cells(提供STR鉴定图谱)
┈订┈购(技术服务)┈热┈线:1┈3┈6┈4┈1┈9┈3┈0┈7┈9┈1【微信同号】┈Q┈Q:3┈1┈8┈0┈8┈0┈7┈3┈2┈4;
GM08579 Cells(提供STR鉴定图谱)
AD-293 Cells;背景说明:详见相关文献介绍;传代方法:1:2传代;生长特性:贴壁生长;形态特性:详见产品说明书;相关产品有:C4-2 Bone metastatic细胞、KYSE 150 KYSE150 Kyse150 KY150
细胞、Hs 888Lu细胞
RCC-4 Cells;背景说明:肾透明细胞癌;男性;传代方法:1:2-1:3传代;每周换液2-3次。;生长特性:贴壁;形态特性:详见产品说明书;相关产品有:A549细胞、KPL1细胞、COLO 320 HSR细胞
NCI-SNU-1 Cells;背景说明:详见相关文献介绍;传代方法:2-3天换液1次。;生长特性:悬浮聚集;形态特性:上皮细胞;相关产品有:HCC-78细胞、MGSMC细胞、MH7A细胞
BV173 Cells;背景说明:慢性粒细胞白血病;男性;传代方法:1:2-1:3传代;每周换液2-3次。;生长特性:悬浮;形态特性:详见产品说明书;相关产品有:RGC-5细胞、RBL.2H3细胞、HS-445细胞
Hs 294T Cells;背景说明:详见相关文献介绍;传代方法:1:2-1:4传代,2-3天换液1次。;生长特性:贴壁生长;形态特性:混合星状和多边形;相关产品有:NTERA-2 clone D1细胞、OVCAR.5细胞、CHL细胞
MES-SA/Dx-5 Cells;背景说明:详见相关文献介绍;传代方法:1:2-1:8传代;每周2-3次。;生长特性:贴壁生长;形态特性:成纤维细胞样 ;相关产品有:RS1细胞、HEK 293T/17细胞、HSCT6细胞
Ba/F3 EGFR-Del19 Cells(提供STR鉴定图谱)
HPAEpiC Cells;背景说明:肺泡;上皮 Cells;传代方法:1:2-1:3传代;每周换液2-3次。;生长特性:贴壁;形态特性:详见产品说明书;相关产品有:Colon-38细胞、IMR-90细胞、hRPTC细胞
ST 486 Cells;背景说明:详见相关文献介绍;传代方法:每2-3天换液;生长特性:悬浮生长 ;形态特性:淋巴母细胞样;相关产品有:HCEC-B4G12细胞、KLN 205细胞、BMF细胞
HDQ-P1 Cells;背景说明:详见相关文献介绍;传代方法:1:2-1:3传代;每周换液2-3次。;生长特性:贴壁或悬浮,详见产品说明书部分;形态特性:详见产品说明书;相关产品有:HCT.116细胞、A-673细胞、HIEC细胞
HSC4 Cells;背景说明:详见相关文献介绍;传代方法:1 x 10^5 cells/10cm dish;生长特性:贴壁生长;形态特性:上皮细胞;相关产品有:H1105细胞、mIMCD-3细胞、NSH细胞
OCILY-19 Cells;背景说明:弥漫大B淋巴瘤;女性;传代方法:1:2-1:3传代;每周换液2-3次。;生长特性:悬浮;形态特性:详见产品说明书;相关产品有:HLEB3细胞、SUM149细胞、CV-1细胞
BALB 3T3 clone A31 Cells;背景说明:胚胎;成纤维;自发永生;雄性;BALB/c;传代方法:1:2-1:3传代;每周换液2-3次。;生长特性:贴壁;形态特性:详见产品说明书;相关产品有:MG-63细胞、PL45细胞、TM-3细胞
WM266 Cells;背景说明:详见相关文献介绍;传代方法:1:2传代;生长特性:贴壁生长;形态特性:详见产品说明书;相关产品有:KE-39细胞、NTERA2-cloneD1细胞、293EBNA细胞
NTERA2 Cells;背景说明:畸胎瘤;男性;传代方法:1:2-1:3传代;每周换液2-3次。;生长特性:贴壁;形态特性:详见产品说明书;相关产品有:NBL-4细胞、NK-92 MI细胞、SW 1353细胞
GM17844 Cells(提供STR鉴定图谱)
HAP1 HTRA2 (-) 4 Cells(提供STR鉴定图谱)
16HBE14o- Cells;背景说明:详见相关文献介绍;传代方法:1:2传代;生长特性:贴壁生长 ;形态特性:详见产品说明书;相关产品有:Panc 3.27细胞、SGC7901细胞、HeLa/S3细胞
SNU668 Cells;背景说明:详见相关文献介绍;传代方法:1:2传代;生长特性:贴壁或悬浮,详见产品说明书部分;形态特性:详见产品说明书;相关产品有:Malme-3M细胞、H-446细胞、DU 4475细胞
SK-N-BE-2 Cells;背景说明:1972年11月从一们多次化疗及放疗的扩散性神经母细胞瘤患儿骨髓穿刺物中建立了SK-N-BE(2)神经母细胞瘤细胞株。 该细胞显示中等水平的多巴胺-β-羟基酶活性。 有报道称SK-N-BE(2)细胞的饱和浓度超过1x106细胞/平方厘米。细胞形态多样,有的有长突触,有的呈上皮细胞样。 细胞会聚集,形成团块并浮起;传代方法:1:2传代;生长特性:贴壁生长;形态特性:上皮细胞样;相关产品有:ID8/MOSEC细胞、BpRc1细胞、SK-CO-1细胞
IPEC-J2 Cells;背景说明:小肠;上皮细胞;自发永生;传代方法:1:2-1:3传代;每周换液2-3次。;生长特性:贴壁;形态特性:详见产品说明书;相关产品有:NT2细胞、Det. 562细胞、ACC-M细胞
hTERTHME1 Cells;背景说明:详见相关文献介绍;传代方法:1:2-1:3传代;每周换液2-3次。;生长特性:贴壁或悬浮,详见产品说明书部分;形态特性:详见产品说明书;相关产品有:SK-MEL-3细胞、PaCa2细胞、LY-R细胞
COLO_320DM Cells;背景说明:该细胞可产生5-羟色胺、去甲、、ACTH和甲状旁腺素。角蛋白、波形蛋白弱阳性。培养条件: RPMI 1640 10%FBS;传代方法:1:2-1:3传代;每周换液2-3次。;生长特性:悬浮+贴壁;形态特性:淋巴细胞;相关产品有:HANK-1细胞、SUDHL-8细胞、H22细胞
P3/NS-1 Cells;背景说明:这是P3X63Ag8(ATCCTIB-9)的一个不分泌克隆。Kappa链合成了但不分泌。能抗0.1mM8-氮杂鸟嘌呤但不能在HAT培养基中生长。据报道它是由于缺失了3-酮类固醇还原酶活性的胆固醇营养缺陷型。检测表明肢骨发育畸形病毒(鼠痘)阴性。;传代方法:1:2传代,3天内可长满。;生长特性:悬浮生长;形态特性:淋巴母细胞;相关产品有:3LL细胞、SUM-102PT细胞、IPLB-Sf21细胞
DH82 Cells;背景说明:肾;Golden Retrieve;传代方法:1:2-1:3传代;每周换液2-3次。;生长特性:贴壁;形态特性:详见产品说明书;相关产品有:IM-95细胞、J774 A1细胞、NCIH1793细胞
HPS0191 Cells(提供STR鉴定图谱)
JHU188i Cells(提供STR鉴定图谱)
MDA-MB-231 NAT1 scrambled Cells(提供STR鉴定图谱)
ND34750 Cells(提供STR鉴定图谱)
PR01398 Cells(提供STR鉴定图谱)
U-2946 Cells(提供STR鉴定图谱)
UM150-4 PGD Cells(提供STR鉴定图谱)
HCA7 colony 24 Cells(提供STR鉴定图谱)
K-562 Cells;背景说明:详见相关文献介绍;传代方法:1:2-1:3传代;每周换液2-3次。;生长特性:贴壁或悬浮,详见产品说明书部分;形态特性:详见产品说明书;相关产品有:GFP-Olig2细胞、Colo205细胞、H3255细胞
WEHI-231 Cells;背景说明:详见相关文献介绍;传代方法:1:2-1:3传代;每周换液2-3次。;生长特性:贴壁或悬浮,详见产品说明书部分;形态特性:详见产品说明书;相关产品有:NCI-H2170细胞、CCC-HPF-1细胞、SW-900细胞
JM1 Cells;背景说明:详见相关文献介绍;传代方法:换液2-3次一周;生长特性:悬浮生长 ;形态特性:淋巴母细胞样;相关产品有:MG-HU-3细胞、MOLT 4细胞、S3-HeLa细胞
MC3T3-E1 Subclone 24 Cells;背景说明:详见相关文献介绍;传代方法:1:2-1:3传代;每周换液2-3次。;生长特性:贴壁或悬浮,详见产品说明书部分;形态特性:详见产品说明书;相关产品有:H1666_DA细胞、526mel细胞、Lung cancer-1/squamous细胞
NIH:OVCAR-8 Cells;背景说明:卵巢癌;女性;传代方法:1:2-1:3传代;每周换液2-3次。;生长特性:贴壁;形态特性:详见产品说明书;相关产品有:X63-Ag8.653细胞、QBI-HEK 293A细胞、IEC-6细胞
NIH:OVCAR-8 Cells;背景说明:卵巢癌;女性;传代方法:1:2-1:3传代;每周换液2-3次。;生长特性:贴壁;形态特性:详见产品说明书;相关产品有:X63-Ag8.653细胞、QBI-HEK 293A细胞、IEC-6细胞
CNE1 Cells;背景说明:详见相关文献介绍;传代方法:1:2-1:3传代;每周换液2-3次。;生长特性:贴壁或悬浮,详见产品说明书部分;形态特性:详见产品说明书;相关产品有:OE33细胞、KMS-11细胞、HEK-293细胞
Virginia Mason Research Center-Renal Cancer Z Cells;背景说明:详见相关文献介绍;传代方法:1:6传代;生长特性:贴壁生长;形态特性:上皮细胞;相关产品有:MDA-PCa-2b细胞、HT-22细胞、293FT细胞
SW 1116 Cells;背景说明:CSAp阴性(CSAp-)。 结肠抗原3,阴性。 角蛋白免疫过氧化物酶染色阳性。 癌基因c-myc, K-ras, H-ras, myb, sis 和fos的表达呈阳性。 未检测到癌基因N-myc和N-ras的表达。 表达肿瘤特异的核基质蛋白CC-4,CC-5和CC-6。;传代方法:消化3-5分钟。1:2。3天内可长满。;生长特性:贴壁生长;形态特性:上皮细胞;相关产品有:WM239A细胞、PF382细胞、MCF-12A细胞
MFE296 Cells;背景说明:详见相关文献介绍;传代方法:1:2传代;生长特性:贴壁生长;形态特性:详见产品说明书;相关产品有:SU-DHL1细胞、CCD-841CoTr细胞、HBL1细胞
NIHOVCAR3 Cells;背景说明:该细胞1982年由T.C. Hamilton等建系,源自一位60卵巢腺癌的腹水,是卵巢癌抗药性研究的模型。;传代方法:1:2—1:4传代,每周换液2—3次;生长特性:贴壁生长;形态特性:上皮细胞样;相关产品有:FL62891细胞、H2052细胞、MC-116细胞
NL20SV Cells;背景说明:支气管上皮细胞;SV40转化;女性;传代方法:1:2-1:3传代;每周换液2-3次。;生长特性:贴壁;形态特性:详见产品说明书;相关产品有:MA-c细胞、NCI-SNU-398细胞、Jiyoye细胞
Earles's cells Cells;背景说明:详见相关文献介绍;传代方法:1:2-1:3传代;每周换液2-3次。;生长特性:贴壁或悬浮,详见产品说明书部分;形态特性:详见产品说明书;相关产品有:BC3 H1细胞、OCI-LY-8细胞、NCI-SNU-C2B细胞
TCC-PAN2 Cells;背景说明:详见相关文献介绍;传代方法:1:2-1:3传代;每周换液2-3次。;生长特性:贴壁或悬浮,详见产品说明书部分;形态特性:详见产品说明书;相关产品有:Suzhou Human Glioma-44细胞、LMH细胞、IOSE-Van细胞
RPMI 8226/S Cells;背景说明:来源于一位61岁的男性浆细胞瘤患者;可产生免疫球蛋白轻链,未检测到重链。;传代方法:按1:2传代,5-6小时可以看到细胞分裂;生长特性:悬浮生长;形态特性:淋巴母细胞样;相关产品有:AC16 [Human hybrid]细胞、NCIH1650细胞、PANC-1细胞
SKOV3.ip1 Cells(提供STR鉴定图谱)
EoL-1 cell Cells;背景说明:急性髓系白血病;男性;传代方法:1:2-1:3传代;每周换液2-3次。;生长特性:悬浮;形态特性:详见产品说明书;相关产品有:Hs746-T细胞、NGP细胞、143BTK-细胞
CHL-1 Cells;背景说明:详见相关文献介绍;传代方法:1:6—1:10传代;生长特性:贴壁生长;形态特性:上皮细胞;相关产品有:NCI-128细胞、HEK/EBNA细胞、MGH-U1细胞
C42 Cells;背景说明:前列腺癌;左锁骨上淋巴结转移;男性;传代方法:1:2-1:3传代;每周换液2-3次。;生长特性:贴壁;形态特性:详见产品说明书;相关产品有:LUDLU-1细胞、1E8-H细胞、PLA 802细胞
AC16人心肌复苏细胞|STR基因图谱
MHCCLM3 Cells;背景说明:详见相关文献介绍;传代方法:1:2传代;生长特性:贴壁生长;形态特性:上皮样;相关产品有:HCC0095细胞、H2110细胞、SNU-719细胞
H2170 Cells;背景说明:该细胞1989年建系,源自一位患有肺鳞状细胞癌的男性,该患者不吸烟;传代方法:1:3—1:6传代,3—5天换液1次;生长特性:贴壁生长;形态特性:上皮细胞;相关产品有:MBdSMC细胞、IM95细胞、MADB 106细胞
G-401 Cells;背景说明:详见相关文献介绍;传代方法:1:2-1:6传代,每周2-3次。;生长特性:贴壁生长;形态特性:上皮细胞样;相关产品有:NCIH889细胞、OC316细胞、Asian Medical Center-Head and Neck cancer-8细胞
┈订┈购(技术服务)┈热┈线:1┈3┈6┈4┈1┈9┈3┈0┈7┈9┈1【微信同号】┈Q┈Q:3┈1┈8┈0┈8┈0┈7┈3┈2┈4;
LIM1215 Cells;背景说明:结直肠癌;男性;传代方法:1:2-1:3传代;每周换液2-3次。;生长特性:贴壁;形态特性:详见产品说明书;相关产品有:HCC44细胞、HL60细胞、MDAMB468细胞
LLC-WRC 256 Cells;背景说明:乳腺癌;雌性;传代方法:1:2-1:3传代;每周换液2-3次。;生长特性:贴壁;形态特性:详见产品说明书;相关产品有:HuNS1细胞、HEEpiC细胞、MHCC-LM3细胞
DHBE Cells;背景说明:支气管;上皮 Cells;传代方法:1:2-1:3传代;每周换液2-3次。;生长特性:贴壁;形态特性:详见产品说明书;相关产品有:SW900细胞、Suzhou Human Glioma-44细胞、Hep 3B2_1-7细胞
F442-A Cells;背景说明:脂肪前体细胞;雄性;Swiss albino;传代方法:1:2-1:3传代;每周换液2-3次。;生长特性:贴壁;形态特性:详见产品说明书;相关产品有:MOLT-16细胞、OVHM细胞、NCIH650细胞
HN 4 Cells;背景说明:喉鳞癌;男性;传代方法:1:2-1:3传代;每周换液2-3次。;生长特性:贴壁;形态特性:详见产品说明书;相关产品有:NTERA2细胞、GM01232E细胞、BBE细胞
Tn-5 Cells;背景说明:详见相关文献介绍;传代方法:1:2-1:3传代;每周换液2-3次。;生长特性:贴壁或悬浮,详见产品说明书部分;形态特性:详见产品说明书;相关产品有:MHCC97H细胞、RAG细胞、NCI-H676B细胞
VM-CUB-1 Cells;背景说明:详见相关文献介绍;传代方法:1:2-1:3传代;每周换液2-3次。;生长特性:贴壁或悬浮,详见产品说明书部分;形态特性:详见产品说明书;相关产品有:MDA-MB436细胞、UPCISCC154细胞、ECV304细胞
RCM1 Cells;背景说明:详见相关文献介绍;传代方法:1:4传代,2-3天换液1次。;生长特性:贴壁生长;形态特性:上皮细胞;相关产品有:H-1993细胞、NCIH1666细胞、AC29细胞
BayGenomics ES cell line DTM098 Cells(提供STR鉴定图谱)
BayGenomics ES cell line XA130 Cells(提供STR鉴定图谱)
CDN02 Cells(提供STR鉴定图谱)
mAB 493 Cells(提供STR鉴定图谱)
Royan C33 Cells(提供STR鉴定图谱)
tHmf-e Cells(提供STR鉴定图谱)
"